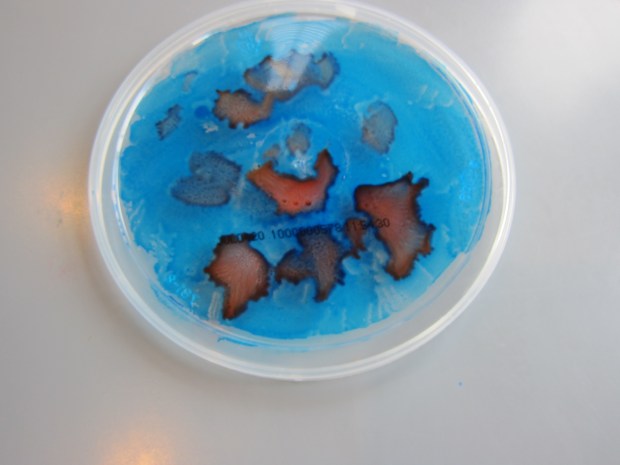
Glow-Bee (2)

The bittersweet moment has come, at 20 months old, that Veronika is ready to wean. Part of me is glad and so proud to see her reach this milestone, but part of me will miss it!
We’re in need, therefore, of a new calm-down bedtime ritual to replace lullabies and breastfeeding. Instead, I’ve started to hug her close as I tell her a story.
Oral stories, rather than simply reading from a page, are a great way to get even young toddlers to imagine and visualize. In fact, we’re enjoying the new ritual so much that my plan is to keep adding to the story nightly. Who knows how long it will go!
Almost anything can be a prompt for an imaginative story like this, but tailor it to your child’s favorite things or activities. Or even use it to address fears that have become apparent in your toddler!
To wit, Veronika’s pajamas made me think of rainbows and unicorns, two of her favorite things.

I began to weave a tale about a girl and her best friend (“Sparkly Neigh”), who is so happy that everywhere she goes, rainbows appear. The tale involves swings, ride-on cars, butterflies, adventures, and more.

What will your story be about? Please share in the comments!